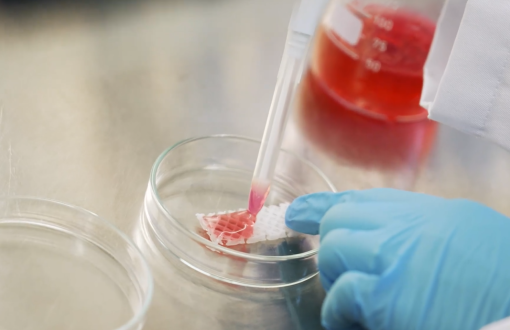
badanie laboratoryjne

Szukasz specjalistycznych badań materiałowych, strukturalnych, biologicznych lub technologicznych?
W naszych laboratoriach badawczych i technologicznych realizujemy szeroki zakres analiz i testów – od mikrostruktury po zaawansowane powłoki funkcjonalne.
Sprawdź, co możemy dla Ciebie wykonać!
Kontakt dla osób zainteresowanych współpracą lub ekspertyzą: dr inż. Marcin Makówka email: marcin.makowka@p.lodz.pl tel. (42) 631 30 74/ 631 30 30 (sekretariat)
Treść (rozbudowana)
Zakres usług: Analiza mikrostruktury materiałów, identyfikacja faz, badania powierzchni i przekrojów poprzecznych.
0
Zakres usług: Analiza składu chemicznego metali, stopów, tworzyw polimerowych, warstw dyfuzyjnych i powłok; badania strukturalne; badania wytrzymałości i twardości materiałów.
0
Lab. Badań Strukturalnych i Fizykochemicznych
Zakres usług: Analiza struktury chemicznej materiałów litych, sproszkowanych i powłok; badania właściwości termicznych; pomiary zwilżalności powierzchni.
0
Zakres usług: Ocena odporności korozyjnej materiałów w różnych środowiskach; badania elektrochemiczne.
0
Zakres usług: Charakteryzacja nanomateriałów; analiza morfologii i struktury; badania właściwości fizykochemicznych.
0
Zakres usług: Badania wytrzymałościowe i tribologiczne materiałów; analiza zachowania pod obciążeniem; ocena odporności na zużycie.
0
Zakres usług: Synteza i charakteryzacja materiałów zol-żel; analiza struktury i właściwości fizykochemicznych.
0
Zakres usług: Pomiary właściwości elektrycznych materiałów; analiza przewodnictwa i rezystywności.
0
Zakres usług: Biologiczna ocena materiałów; badania cytotoksyczności; analiza interakcji materiałów z komórkami i tkankami.
0
Zakres usług: Modyfikacja i funkcjonalizacja materiałów dwuwymiarowych; analiza właściwości powierzchniowych.
0
Zakres usług: Druk 3D w technologiach FFF, SLA, MSLA; projektowanie i prototypowanie obiektów; edukacja w zakresie technologii przyrostowych.
0
Zakres usług: Biodruk 3D struktur biologicznych; badania właściwości biomateriałów; analiza interakcji z komórkami.
0
Zakres usług: Osadzanie cienkich powłok metodą RF PE CVD; modyfikacja powierzchni materiałów; nakładanie powłok Parylenowych.
0
Zakres usług: Wytwarzanie powłok supertwardych, niskotarciowych, żaroodpornych, barier termicznych; osadzanie powłok dekoracyjnych i funkcjonalnych.
0
Lab. Technologiczne PVD+CVD dla Medycyny
Zakres usług: Wytwarzanie powłok dla zastosowań medycznych; modyfikacja powierzchni biomateriałów; osadzanie powłok antybakteryjnych i bioaktywnych.
0
Zakres usług: Modyfikacja właściwości materiałów poprzez obróbkę cieplną; hartowanie, nawęglanie, azotowanie; obróbka cieplno-chemiczna.
0